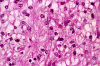
Com401-2-Perm06.gif (133968 bytes)

Squash
Squash
Squash
Squash
Frozen
Frozen


Frozen
Frozen
| A 5 year-old Boy with
Nausea and Vomiting for Three Months. January, 2004, Case 401-2. Home Page |
Newton Agrawal, S.B. (MS-IV)1, Kar-Ming Fung, M.D., Ph.D.2 Last updated January 30, 2004.
1 Fourth year medical student, Class of 2004, College of Medicine, University of Oklahoma, 2 Department of Pathology, University of Oklahoma Health Sciences Center, Oklahoma City, Oklahoma
Clinical information:
The patient was a 5 year-old boy who developed intermittent nausea and vomiting. Three days before admission, his conditions deteriorated to the point that he was not able to hold down any food because of regular vomiting. A large mass in the posterior fossa was found on CT scan in an outside hospital. He was transferred to our institution for further evaluation and treatment. On initial admission, the patient was mildly somnolent but could interact normally. He also complained of mild headache. On neurologic examination, he had some difficulties with upward gaze. Otherwise he was neurologically intact. There was no weakness in the extremities.
MRI scan was performed and revealed a solitary, large, intraxial mass in the right cerebellar hemisphere. It compressed the 4th ventricle and causing obstructive hydrocephalus of the third and lateral ventricle and there is also mild leftward midline shift. The mass had internal cystic changes and a mural component. The mass was hypointense on T1-, hyperintense on T2 weighed images and was enhancing. Some curvilinear area of decreased signal intensity on both T1- and T2-weighed images suggesting calcifications were present.
 |
 |
 |
 |
 |
 |
|
A. Squash |
B. Squash |
C. Squash |
D. Squash |
E. Frozen |
F. Frozen |
 |
 |
||||
|
G. Frozen |
H. Frozen |
 |
 |
 |
 |
|
 |
| I. | J | K. | L. | M. | N. |
 |
 |
 |
 |
 |
 |
| O. | P. | Q. | R. |
S. Jones stain |
T. Jones stain |
Pathology of the case:
Comment: This case illustrated the diversified histologic features that can be seen in some pilocytic astrocytomas.
|
DIAGNOSIS: Pilocytic astrocytoma. (WHO grade I/IV) |
Discussion: General Information Imaging Gross pathology Histopathology Differential diagnosis
General Information
“Pilocytic” refers to hair-like, which often describes the presence of long,
bipolar processes. Pilocytic astrocytomas were first decribed by Ribbert
in 1918. However, it was not until 1931, when Wilder Penfield coined the term piloid
astrocytomas. In 1993, the
WHO classified piloid tumors with a biphasic pattern of tightly packed bipolar
cells intermixed with looser microcystic areas of protoplasmic astrocytes as pilocytic astrocytomas
with a histologic grade of I/IV.
Pilocytic astrocytoma is the most common benign
neoplasm of the central nervous system of childhood. They represent 6% of all intracranial tumors and have an incidence of 1
in 100,000 per year. The peak age of occurrence is between 8 and 13 years
of age, with a far lower likelihood of occurrence in adulthood. The tumor
has an equal predilection for occurring in either males or females.
Pilocytic astrocytomas
affect midline structures with cerebellum as the most common location. Pilocytic
astrocytomas occurring in the optic nerve-hypothalamus are most common in
patients with neurofibromatosis 1. Complications from chiasmal and hypothalmic
involvement may include endocrinopathies. Tumors occuring in the thalamus, brainstem,
and cerebellum may include produce hydrocephalus. , Parinaud's syndrome
may occur when the pineal region is involved. In adults, these tumors are often
found in the temporoparietal region of the
cerebral hemispheres.
In general, pilocytic astrocytomas have a favorable prognosis with surgical resection. Gross total resection usually lead to a cure. In patients with subtotal resection, the 10-year survival was found to be greater than 80%. Recurrence is uncommon. Very rarely, they may disseminate throughout the central nervous system. Click here to see a case of disseminated pilocytic astrocytoma
On CT, one typically finds sharply demarcated and smoothly marginated isodense or hypodense regions displaying round to oval lesions or cystic structures. Calcification of cysts is common. On MRI, they are isodense or hypodense on T1-weighted images, and hyperintense on T2-weighted images. Pilocytic astrocytoma often occurs as cystic structure or a generalized fusiform enlargement of midline structures; these features help differentiate pilocytic astrocytomas from other gliomas. Typical structures to examine are the optic nerve for fusiform enlargement, the optic chiasm for globular mass, the dorsal brain stem for exophytic lesions, the spinal cord for fusiform thickening, or supratentorial regions for mass. Tumors arising from in the optic chiasm may not appear as clearly demarcated as other tissues and can often easily be confused with craniopharygiomas and suprasellar germinomas. Ventricular involvement particularly the third ventricle may also occur. On PET scan, affected regions exhibit increased glucose uptake. Click here to see the image of another case
Pilocytic astrocytomas grow as an expansile mass ratherr than
infiltration. In the cerebellum, they are usually well circumscribed. In
other sites such as the optic nerve, the demarcation is not as clear. The
tumor is often tough, elastic, firm, but may also be partly mucoid. The cut
surface is grayish-pink and show mucoid degeneration.
Degeneration into small and large cysts are seen in over 80% of the
cases. Because of their rich vascularity, hemosiderin depositions are common in
older tumors. Pilocytic astrocytoma has a tendency to penetrate the
leptomeninges and induce desmoplastic reaction. They may have
extensive leptomeningeal spread but this feature does not indicate biological
malignant behavior.
Microscopically, pilocytic astrocytomas characteristically contain alternating densely packed areas and loosely packed areas. The cellularity is moderate but can be focally hypocellular or hypercellular. The tumor cells have elongated, coarse, hair-like cytoplasmic processes. The nuclei are usually bland, small to medium sized and has open chromatin. A variety of patterns can be seen. The loose tissue is composed of minute vacuoles, microcysts, and eosinophilic fluid-filled spaces, which can coalesce into larger structures. A variety of histologic patterns as illustrated in this case can be found. Rosenthal fibers, varying in amount from a few to substantial, may be found and are particularly common in the fibrillary areas. Eosinophilic granular bodies are aggregates of eosinophilic globules and they are often found in pilocytic astrocytoma. Their presence is related to the benign nature of these tumors. Glomeruloids of blood thin walled blood vessels are also common findings. Extension into the leptomeninges is common and does not signify malignant behavior. Tumor necrosis is an uncommon features and should be distinguished from infarction of tumor. In longstanding cases, degenerative atypia may occur. The proportion of cycling cells as measured by immunohistochemistry for Ki67 is usually under 5%. Occasional mitoses may be found but they are not indication of aggressive behavior.
Pilomyxoid astrocytoma share the same incidence and localization as classic pilocytic astrocytomas but appear to occur more frequently in the hypothalamus and occasionally in the cerebellum. They are more likely to re-occur locally or seed the ventricles.
Differential diagnosis
Similar to pilocytoc astrocytoma, ganglioglioma is also solid, may have cystic changes, non-infiltrative, and may have Rosenthal material. Ganglioglioma in the cerebellum is uncommon. Careful search for the dysmorphic neurons is the key to correct diagnosis.
Diffuse astrocytoma of WHO grade II or III must be separated from pilocytic astrocytoma for their very different prognosis. The characteristic imaging features of enhancement without perilesional edema, cystic and solid component of a pilocytic astrocytoma is also very helpful. Histologically, diffuse astrocytoma lack the biphasic pattern, the piloid appearance and, usually, Rosenthal fibers. The endothelial proliferation in high grade astrocytomas must not be confused with the glomeruloids of vessels in pilocytic astrocytomas.
Pilocytic astrocytoma shares features with some long standing gliosis. In supratentorial locations, long standing gliosis are most commonly seen in the hypothalamus around a craniopharyngioma or in the cyst wall of a cerebellar hemangioblastoma. These long standing gliosis share the piloid features and presence of Rosenthal fibers with pilocytic astrocytoma and are termed piloid gliosis. There is no absolute criteria for the distinction of pilocytic astrocytoma from piloid gliosis. Identification of the underlying pathologic changes that lead to piloid gliosis is always very helpful. The lack of characteristic glomeruloids of blood vessels in pyloid gliosis a useful feature.
Alexander's disease is a leukodystrophy that is seen most commonly in infants or later childhood and is clinically a progressive, sometimes very slow, process with dementia, seizures and spasticity. Pathologically, it is also characterized by widespread accumulation of Rosenthal fibers. Initially, the Rosenthal material accumulates in the astrocytic cell body but eventually located at the end-feet. There is also gliosis and extensive myelin disintegration. Rosenthial fibers are found throughout CNS but are most commonly seen in subpial, subependymal, and perivascular sites and their distribution does not always correlate with the myelin loss and can be found in areas without myelin abnormalities such as pontine tegmentum. Astrocytes contain eosinophilic globules with ultrastructural features of Rosenthal material. Nuclear atypia can also occur in the astrocytes. Progression of Alexander's disease is usually symmetrical and involves the frontal lobes with extension into thetemporal and parietal lobes. The clinical and imaging features usually allows recognition without biopsy. The etiology is related to mutations of the glial fibrillary acidic protein (GFAP).
Further reading:
Burger PC, Sheithauer BW, Vogel FS. Surgical Pathology of the Nervous System and its Coverings. 4 edt. Church Livingstone. 2002. pp 203-215.
Greenberg HS, Chandler WF, and Sandler HM. Pilocytic Astrocytoma, Low-Grade Astrocytoma, and other "Benign" Neuroepithelial Neoplasms. Brain Tumors. 1999. Oxford University Press: New York. 168-173.
Cohen ME and Duffner PK. Supratentorial Hemispheric Astrocytomas. Brain Tumors in Children. 1994. 2nd edition. Raven Press: New York. 265-284.
Zulch KJ. Pilocytic Astrocytomas. Brain Tumors: Their Biology and Pathology. 1986. 3rd edition. Springer-Verlag: New York. 221-222.
Brenner M, Johnson AB, Boespflug-Tanguy O, Rodriguez D, Goldman JE, Messing A. Mutations in GFAP, encoding glial fibrillary acidic protein, are associated with Alexander disease. Nat Genet. 2001 Jan;27(1):117-20.